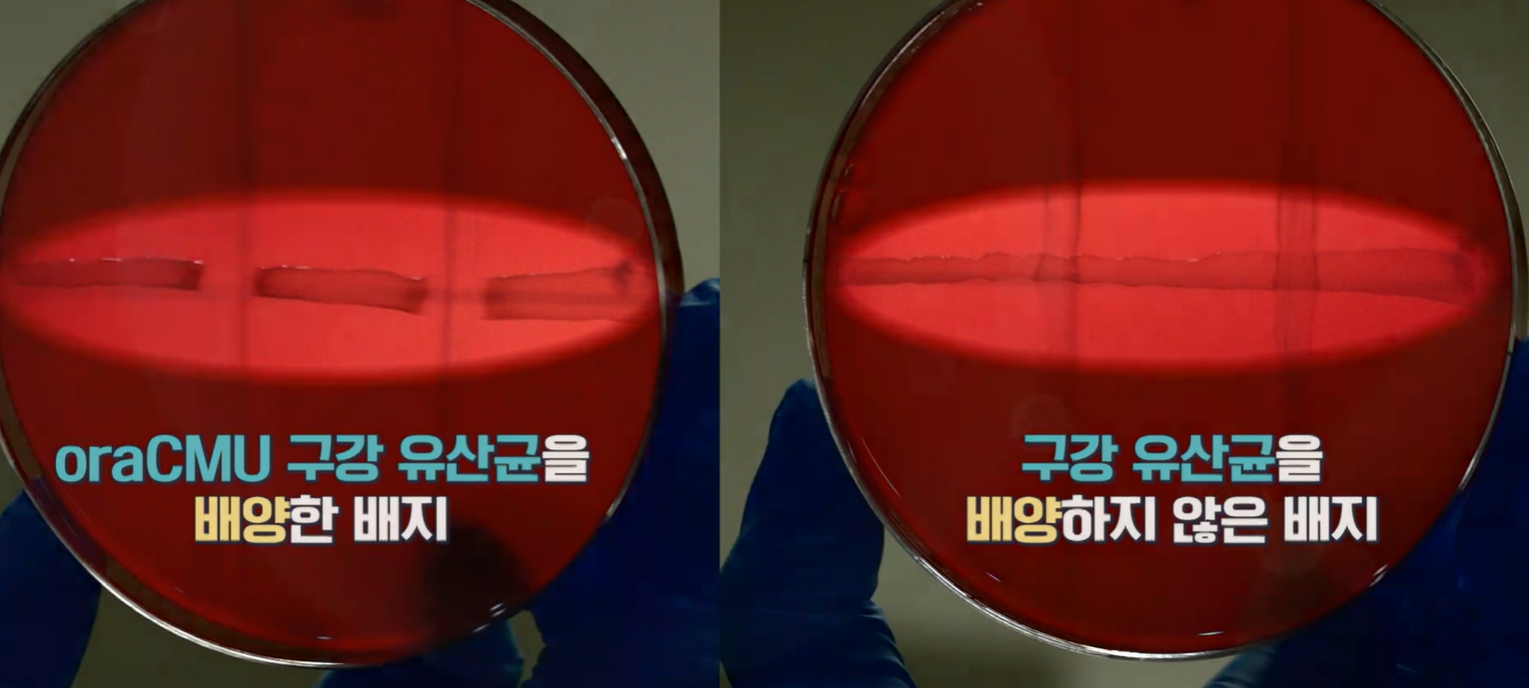

티스토리 뷰
코로나 때는 마스크를 쓰고 다녀서 몰랐는데 마스크 해제 후 입냄새로 고민하는 분들이 많습니다. 입냄새 원인 제거에 도움을 주는 구강유산균 효과, 부작용 정리해 드리겠습니다.

1. 입냄새 원인


입 냄새의 원인은 구강 내 원인과 구강 외 호흡기 문제, 편도결석, 코 내부 염증, 소화기계 문제 등 다양합니다. 하지만 대부분 구취의 주 발생원인 중 80~85%는 구강 내 원인입니다.
입안에서 충치를 일으키거나 잇몸 질환을 일으키는 입속 세균들이 구강 점막에서 탈락하는 세포들과 음식 먹고 남은 찌꺼기, 침 속에 들어있는 단백질 성분들을 부패시켜 악취를 유발하는 가스를 만들어냅니다.
대한민국 청소년 이상 구취 인구 비율은 20%로 5명 중 1명이 구취로 고민하고 있습니다.
2. 구강유산균 효과



1) 구강 건강 개선 효과
우리 입 안에는 유익한 균과 유해한 균이 함께 존재하고, 이들 균들은 서로 균형을 유지하면서 살아갑니다. 그러나 이 균형이 깨지면 유해한 균이 너무 많아져 각종 구강질환을 발생시킵니다.
이때 유익한 균을 증식시켜 유해한 균의 활동을 억제하는데 도움을 주는 것이 구강유산균입니다. 실제로 윔 투겔 교수는 구강유산균을 이용한 환자들이 천명 이상이며, 치주염, 치은염, 구취 등의 질환을 가진 환자들이 구강유산균을 사용하면 많은 도움을 받았다고 합니다.
따라서 구강유산균은 구강 건강에 긍정적인 효과를 줄 수 있는 음식 중 한 가지입니다. 구강유산균이 충분히 존재하는 음식은 구강 건강뿐만 아니라 식도나 위장, 대장 등 다양한 장기의 건강에도 도움이 된다는 연구 결과도 있습니다.
2) 유익균 증식 효과


구강 건강을 지키기 위해서는 유익한 균과 유해한 균의 균형을 유지하는 것이 중요합니다. 유익한 균을 늘리고 유해한 균과의 균형을 맞추기 위해 구강 유산균을 적극적으로 섭취해 보는 것이 좋습니다.
실제로 건강한 구강에서 채취한 구강유산균은 충치억제균 등 유익한 균을 적극적으로 증식시키는 것으로 확인되었습니다. 이를 통해 충치 유발 세균, 치주 질환 유발 세균, 구강 조직 파괴 세균 등 유해한 균을 억제할 수 있다는 연구 결과가 있습니다.
따라서 구강 건강을 지키기 위해 구강 유산균을 섭취하는 것은 유익한 균을 증식시키고 유해한 균을 억제해 구강 질환을 예방하는 데에 큰 도움이 됩니다.
3) 구강질환 개선 효과

구강질환은 언제든 발생할 수 있는 위험한 질병 중 하나입니다. 이런 질병을 예방하고 치료하려면 구강 유산균을 활용하는 것이 좋습니다.
실제로 건강한 어린이의 구강에서 채취한 구강유산균을 배양해본 결과, 대표적인 구강질환 유발균인 진균에 대해 구강 유산균이 적극적으로 작용했음을 확인할 수 있었습니다.
또한, 치주질환자에게 8주간 구강유산균을 섭취해본 결과, 출혈 지수와 미생물군이 개선되었으며, 섭취하지 않은 그룹과 비교하여 출혈 지수가 더욱 향상되었음이 밝혀졌습니다.
따라서 구강질환 예방과 치료에 구강 유산균을 섭취하는 것은 효과적인 방법 중 하나입니다.
4) 구취 개선 효과

구취로 인해 고생하는 분들이 많이 계실 것입니다. 이런 경우 양치를 잘해도 구취가 개선되지 않을 수 있습니다. 그러나 구강 유산균을 섭취한다면 구취를 유발하는 유해균을 억제하여 구취개선에 도움을 줄 수 있습니다.
실제로 구강유산균을 섭취한 후 구취 정도를 확인할 수 있는 황화수소와 메틸메르탑의 수준이 감소한 것으로 알려져 있으며, 윔 투겔 교수는 구강 유산균 섭취로 구취가 약 50% 줄어드는 것으로 나타났다고 합니다.
5) 병원균 밸러스 효과
구강에는 세균이나 바이러스와 같은 나쁜 세균이 들어올 수 있습니다. 하지만 구강 안에 있는 유익한 세균과 함께 나쁜 세균과의 밸런스를 맞춰주면 병원을 일으키는 세균들을 조절할 수 있습니다.
구강유산균은 다양한 기능을 가지고 있는데 그 중 하나가 구강 내 나쁜 세균들을 억제하는 기능입니다. 또한, 나쁜 세균과 경쟁을 하는 세균들이 구강 내에서 이김으로써 나쁜 세균의 성장을 억제하는데도 도움을 줍니다.
따라서 구강 유산균을 적극적으로 챙겨먹으면 구강 내의 나쁜 세균들을 억제하고, 유익한 세균들과 밸런스를 잡아주는 데 많은 도움을 줄 수 있습니다.
3. 구강유산균 부작용

구강 유산균은 이미 우리 구강 내에서 존재하는 유익한 세균입니다. 따라서 구강 유산균을 섭취하면 거의 부작용은 없습니다.
그러나 섭취량을 과도하게 먹거나 처음 먹을 때는 며칠 동안 복통, 설사 등 구강유산균 부작용이 발생할 수 있으므로 주의해야 합니다.
또한, 감염 위험이 높은 경우나 아이, 임산부 등은 의사와 상의한 후 구강 유산균을 섭취하시는 것이 좋습니다. 따라서 구강 유산균을 적극적으로 섭취하여 건강한 입속과 구강을 유지할 수 있도록 노력하되, 섭취하는 양과 시기를 조절해 안전하고 효과적으로 섭취하여 보호하시길 바랍니다.
'건강 정보' 카테고리의 다른 글
| 비타민D 부족 증상 한번에 정리 (0) | 2023.05.23 |
|---|---|
| 쿠바산 폴리코사놀의 효능, 복용법, 부작용, 가격 비교, 하루섭취량 정리 (0) | 2023.05.23 |
| bnr17유산균 효능, 부작용, 복용법, 가격비교, 추천 (0) | 2023.05.20 |
| 카무트 효소 분말 효능, 가격, 부작용, 고르는 법 정리 (1) | 2023.05.19 |
| 낙산균이란, 프로바이오틱스 효능, 부작용, 가격, 복용법 정리 (0) | 2023.05.18 |